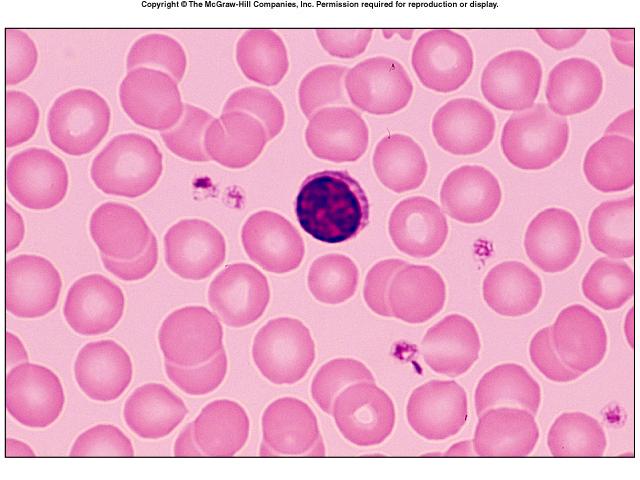

Instructions for Side by Side Printing
- Print the notecards
- Fold each page in half along the solid vertical line
- Cut out the notecards by cutting along each horizontal dotted line
- Optional: Glue, tape or staple the ends of each notecard together
blood
front 1 what kind of tissue is blood? | back 1 connective tissue |
front 2 what are the two components of blood | back 2 plasma and formed elements |
front 3 what are the formed elements in blood | back 3 erythrocytes, leukocytes and thrombocytes |
front 4 what are erythorocytes | back 4 red blood cells or RBC's |
front 5 what are leukocytes | back 5 white blood cells or WBC's |
front 6 what are thrombocytes | back 6 platelets |
front 7 hematocrit | back 7 the percentage of blood volume that is red blood cells 47%(+ or -) for males and 42%(+ or -) for females |
front 8 what are the physical characteristics of blood | back 8 sticky, opaque fluid
|
front 9 one of the functions of blood is distribution explain | back 9 distributes oxygen and nutrients to body cels
|
front 10 one of the functions of blood is regulation explain | back 10 regulates body temperature by absorbing and distributing heat
|
front 11 what is the most important regulatory function of the blood | back 11 regulating body temperature |
front 12 one of the functions of blood is protection explain | back 12 protects against blood loss - plasma proteins and platelets initiate clot formation
|
front 13 what is one area where blood doesnt go | back 13 cartilage |
front 14 what is blood plasma composed of | back 14 90% water, proteins, nutrients, electrolytes, respiratory gases, hormones, and nitrogenous by products of metabolism |
front 15 blood plasma - where are most of the proteins produced, what are the proteins,and what role do they play | back 15 mostly produced by the liver
|
front 16 what are the nitrogenous by products of metabolism in blood plasma | back 16 lactic acid, urea, creatine |
front 17 what nutrients are found in blood plasma | back 17 glucose, carbohydrates, amino acids |
front 18 what are the electrolytes found in blood plasma | back 18 Na K Ca Cl and HCO |
front 19 respiratory gases found in blood | back 19 oxygen and carbon dioxide |
front 20 which blood cells are the only complete blood cells and why | back 20 White blood cells - because they contain a nucleus |
front 21 which blood cells contain no nuclei or organelles | back 21 red blood cells |
front 22 platelets are considered what | back 22 cell fragments |
front 23 how long do most formed elements survive in the blood stream | back 23 only a few days |
front 24 where do most blood cells originate | back 24 bone marrow - and dont divide |
front 25 describe an erythrocyte | back 25 red blood cell, biconcave discs, anucleate (no nucleus) essentially no organelles, filled with hemoglobin, are the major contributing factor to blood viscosity |
front 26 why does a RBC have a biconcave shape | back 26 to give it a huge surface area relative to volume |
front 27 an RBC has no mitochondia so how does it produce ATP | back 27 ATP production is anaerobic - which means no oxygen is used to generate ATP, and they are not consuming any of the oxygen that they are carrying |
front 28 what fills a RBC | back 28 97% hemoglobin - for gas transport |
front 29 where can you find spectrin and what is its function | back 29 on the cytoplasmic face of the plasma membrane - it gives the RCS the flexibility to change shape as necessary as it passes through capilaries and then to resume its biconcave shape. |
front 30 what is the job of RBC's | back 30 to transport respiratory gases - oxygen and carbon dioxide |
front 31 what is the job of hemoglobin and what is it made up of | back 31 to bind oxygen to the RBC (also what makes RBC's red)
|
front 32 oxygemoglobin | back 32 oxygen loading in the lungs - (ruby red) |
front 33 deoxyhemoglobin | back 33 unloading of oxygen in the tissues - reduced hemoglobin (dark red) |
front 34 carbminohemoglobin | back 34 carbon dioxide unloading in the tissues (carries 20% of carbon dioxide in the blood) occurs from tissues to lungs where carbondioxide is eliminated from the body |
front 35 what is hematopoiesis | back 35 hema - blood poiesis - to produce
|
front 36 where can 75% of bicarbonate be found | back 36 in the plasma |
front 37 explain what hemocytoblasts are | back 37 stem cells, give rise to all formed elements |
front 38 97% of oxgen is carried by the RBC's what happens to the rest of it | back 38 the rest is disolved as a gas in the blood |
front 39 CO2 is converted to what? the rest is converted to what? | back 39 HCO3
|
front 40 what happens when carbondioxide binds to hemoglobin | back 40 it gets rid of the oxygen |
front 41 what does the heme portion of the blood carry | back 41 iron |
front 42 erythropoieses | back 42 the process of red blood cell production happens in the red bone marrow |
front 43 explain the process of erythropoiesis | back 43 begins with the stem cell(hemocytoblast), hormones (erythropoitein EPO)circulating in the blood stream stimulate the cell to become a committed cell, the cell then beomes a proerythroblast at that time huge amounts of ribosomes are produced, next comes phase 1 (early erythroblast) ribosome sythesis occurs then phase 2 (late erythroblast) hemoglobin is sythesized and iron accumulates within the cell, it then becomes a normoblast, when most of the hemoglobin has accumulated the organelles are ejected. phase 3 the nuclear functions end and the nucleus degenerates and is ejectedwhich causes the cell to colapse giving it the biconcave shape resulting in a reticulocyte. |
front 44 how long does the process of erythropoiesis take | back 44 about 15 days |
front 45 what happens if you dont have enough RBC's | back 45 leads to tissue hypoxia - inadequate oxygen supply to the tissues |
front 46 what happens if you have too many RBC's | back 46 an increase in blood viscosity |
front 47 the balance between RBC production and destruction depends on what | back 47 hormonal controls and adequate supplies of iron, amino acids and B vitamins |
front 48 describe the erythropoietin EPO process | back 48 1. stimulus - hypoxia(low blood O2 carrying ability) decreased RBC count, decreased hemoglobin, decreased availibility of oxygen
|
front 49 what is erythropoietin EPO | back 49 a glocoprotein hormone which directly stimulates erythropoiesis, which is released by the kidneys in response to hypoxia |
front 50 what are causes of hypoxia | back 50 hemorrage or increased RBC destruction, insuficient hemoglobin (iron deficiency) and reduced availability of oxygen (high altitudes) |
front 51 what are the effects of EPO | back 51 more rapid maturation of committe bone marrow cells
|
front 52 what also enhances EPO production leading to higher RBC counts in males | back 52 testosterone |
front 53 what is the hematocrit? what is its normal value | back 53 the percentage of blood that is occupied by erythrocytes - it is normally about 45% |
front 54 list two protective funcions of blood | back 54 formation of clots - to prevent blood loss
|
front 55 are plasma proteins used as fuel for body cells - explain | back 55 no their presence in the blood is required to perform many key functions |
front 56 Differentiate into macrophages | back 56 Monocyte |
front 57 Form a temporary plug at the site of bleeding | back 57 Platelets |
front 58 what are some of the, dietary requirements required for erythropoiesis | back 58 amino acids, lipids, and carbohydrates
|
front 59 Where / how is iron stored and transported | back 59 65% is stored in the hemoglobin,also in the liver, spleen, and bone marrow
|
front 60 what is Vitamin B12 and folic acid necessary for | back 60 DNA synthesis and cell division |
front 61 what is the lifespan of a RBC | back 61 100 to 120 days |
front 62 what is the life cycle of a red blood cell | back 62 1. low O2 levels in blood stimulate kidneys to produce EPO
|
front 63 what happens to hemoglobin once it is broken down | back 63 the heme and the globin are seperated
|
front 64 what are some erythrocyte disorders | back 64 anemia and polycythemia |
front 65 what is anemia | back 65 when blood has abnormally low oxygen carrying capacity - its a sign rather than a disease, blood oxygen levels cant support normal metaboolism, accompanied by fatigue, paleness, shortness of breath and chills |
front 66 what are some causes of anemia | back 66 1. insufficient erythrocytes
|
front 67 describe insufficient erythrocytes | back 67 1. hemorrhagic anemias
|
front 68 describe hemorrhagic anemias | back 68 acute or chronic blood loss |
front 69 describe hemolytic anemias | back 69 RBC's rupture prematurely |
front 70 describe aplastic anemias | back 70 destruction or inhibition of red bone marrow |
front 71 describe low hemoglobin content | back 71 1. iron deficiency anemia
|
front 72 describe iron deficiency anemia | back 72 secondary result of hemmorrhagic anemia or inadequate intake of iron-containing foods or impaired iron absorption |
front 73 describe prenicious anemia | back 73 deficiency of vitamin B12
|
front 74 describe abnormal hemoglobin | back 74 1. thalassemias
|
front 75 describe thalassemias | back 75 absent or faulty globin chain
|
front 76 describe sickle-cell anemia | back 76 defective gene codes for abnormal hemoglobin (HbS)
|
front 77 aplastic | back 77 from the start |
front 78 hemmorrhagic | back 78 older |
front 79 how many molecules of oxygen can each hemoglobin molecule transport? what part of hemoglobin binds the oxygen? | back 79 each hemoglobin molecule can transport four O2
|
front 80 patients with advanced kidney disease often have anemia - explain the connection | back 80 the kidneys synthesis of erythropoietin is compromised in advancded kidney disease
|
front 81 what is polycythemia and what does it result from | back 81 an excess of RBC's that increases blood viscosity
|
front 82 what is blood doping | back 82 the practice of boosting the number of red blood cells (RBCs) in the bloodstream in order to enhance athletic performance. |
front 83  | back 83 red blood cell
|
front 84 leukocytes | back 84 white blood cells
|
front 85 diapedesis | back 85 The migration of blood cells (especially leucocytes) through the intact walls of blood vessels into the surrounding tissue
|
front 86 what is leukocytosis | back 86 when the WBC count is over 11,000/mm3 - normal response to a viral invasion |
front 87 granulocytes | back 87 neutrophil
|
front 88 formation of neutrophils | back 88 leukocytes arise from ancestral stem celss called hemocytoblats
|
front 89  | back 89 neutrophil
|
front 90 formation of eosinophil | back 90 leukocytes arise from ancestral stem celss called hemocytoblats
|
front 91  | back 91 eosinophil
|
front 92 formation of basophil | back 92 leukocytes arise from ancestral stem celss called hemocytoblats
|
front 93  | back 93 basophil - rarest WBC
|
front 94 histamine | back 94 an inflammitory chemical that acts as a vasodilator and attracts other WBC's to inflammed sites |
front 95 agranulocytes | back 95 lymphocytes and monocytes
|
front 96 lymphocyte formation | back 96 leukocytes arise from ancestral stem cells called hemocytoblats
|
front 97 | back 97 lymphocyte
|
front 98 how many types of lymphocytes are there and what do they do | back 98 there are 2 types
|
front 99 monocyte formation | back 99 leukocytes arise from ancestral stem celss called hemocytoblats
|
front 100  | back 100 monocyte - the largest leukocyte
|
front 101 leukopoiesis | back 101 production of white blood cells
|
front 102 leukocyte disorders include what | back 102 leukopenia - abnormally low WBC count - drug induced
|
front 103 what sort of cells are involved in acute leukemia? who is primarily affected by this disease | back 103 blast type cells
|
front 104 leukemia | back 104 bone marrow totally occupied with cancerous leukocytes, immature nonfunctional WBC's in the bloodstream, death is caused by internal hemorrhage ans overwhelming infections, treatments include irradiation, antileukemic drugs, and stem cell transplants |
front 105 cases of chronic leukemia more prevelant in what age group | back 105 older people |
front 106  | back 106 thrombocytes - platelets
|
front 107 which WBC's turn into macrophages in tissues? which other WBC is a voracious phagocyte? | back 107 noocytes become macrophages in tissues
|
front 108 platelets are called thrombocytes in other animals. which term that we have learned relates to its name? what does this term mean? | back 108 thrombopoietin is derived from the same word as thrombocyte
|
front 109 Amos has leukemia. even though his WBC count is abnormally high. Amos is prone to severe infections, bleeding, and anemia - explain. | back 109 his red bone marrow is spewing out many abnormal WBC's which are crowding out the production of normal bone marrow elements
|
front 110 thrombopoietin - | back 110 thrombocytes |
front 111 formation of platelets | back 111 stem cell hemocytobalst
|
front 112 homestasis - stop bleeding | back 112 step 1 vascular spasm - smooth muscle contracts causing vasoconstriction
|
front 113 what are the three phases of coagulation | back 113 1. prothrombin activator is formed when tissue is damaged A)intrinsic pathway- factors present within blood stimulate coagulation B) extrinsic coagulation- factors outside blood stimulate coagulation
|
front 114 thromboembolytic disorders | back 114 undesirable clot formation |
front 115 bleeding disorders | back 115 abnormalities that prevent normal clot formation |
front 116 thrombus | back 116 clot that developes and persists in an unbroken blood vessel - may block circulation, leading to tissue death |
front 117 embolis | back 117 thrombus freely floating in the blood stream
|
front 118 how can thromboembolytic conditions be prevented | back 118 aspirin- antiprostaglandin that inhibits thromboxane A2
|
front 119 disseminated intravascular coagulation | back 119 widespread clotting blocks intact blood vessels
|
front 120 petechia | back 120 A petechia ( /pɨˈtiːkiə/; plural petechiae /pɨˈtiːkɪ.iː/) is a small (1-2mm) red or purple spot on the body, caused by a minor hemorrhage (broken capillary blood vessels).[1 |
front 121 thrombocytopenia | back 121 dificient number of circulating platelets
|
front 122 impaired liver function may also cause bleeding dsorders - explain | back 122 a. inability to synthesize procoagulants
|
front 123 hepatitis | back 123 Hepatitis is swelling and inflammation of the liver. It is not a condition, but is often used to refer to a viral infection of the liver |
front 124 cirrhosis | back 124 Cirrhosis is scarring of the liver and poor liver function. It is the final phase of chronic liver disease. |
front 125 hemophilias include several similar hereditary bleeding disorders describe A B and C | back 125 hemophilia A - most common type (77% of all cases) due to a deficiency of factor VIII
|
front 126 one of the symptoms of hemophilia is prolonged bleeding, where does this occur | back 126 in the joint cavities |
front 127 how are bleeding disorders treated | back 127 with plasma transfusions and injection of missing factor |
front 128 what is a whole blood tranfusion | back 128 when blood loss is substantial |
front 129 when are infusions of packed red cells | back 129 when whole blood from which most of the plasma has been removed is used to restore oxygen carrying capacity |
front 130 what can occur if a transfusion of incompatible blood is given | back 130 it can be fatal |
front 131 how many different varieties of naturally occuring Rbc antigens do humans have | back 131 30 |
front 132 what do antigens of the ABO and Rh blood groups cause | back 132 vigorous transfusion reactions |
front 133 what are the blood types | back 133 A
|
front 134 antigen - agglutinogens | back 134 An antigen that stimulates the production of a particular agglutinin, such as an antibody. Also called agglutogen |
front 135 antibodies - agglutinins | back 135 An antibody that causes particulate antigens such as bacteria or other cells to clump together. |
front 136  | back 136 antigens photo |
front 137 blood group AB | back 137 antigen (agglutinogens): A B
|
front 138 blood group B | back 138 antigen (agglutinogens): B
|
front 139 blood group B | back 139 antigen (agglutinogens) : A
|
front 140 blood group O | back 140 antigen (agglutinogens) : none
|
front 141 how many different Rh agglutinogens are there | back 141 45 different Rh agglutinogens (Rh factors)
|
front 142 when do transfusion reactions occur | back 142 if mismatched blood is infused |
front 143 when transfusion reactions occur what happens to the donors cells | back 143 they are attacked by the recipients plasma agglutinins, agglutinate and clog small vessels, rupture and release free hemoglobin into the bloodstream |
front 144 when transfusion reactions occur what does it result in | back 144 diminished oxygen carrying capacity
|
front 145 what is erythroblast fetalis | back 145 hemolytic disease of the newborn the Rh- mother becomes sensitized when exposure to Rh+ blood occurs and causes her body to synthesize Rh antibodies which cross the placenta and destroy the RBC's of the Rh+ baby the baby can be treated with prebirth abd after birth transfusions - RhoGAM serum containing anto Rh can prevent the Rh- mother from becoming sensitized |
front 146 what can result from low blood volume | back 146 death from shock |
front 147 how can low blood volume be replaced immediately | back 147 a. with normal saline or multiple electrolyte solution that mimics plasma electrolyte composition
|
front 148 diagnostic blod tests include what | back 148 1. hematocrit
|